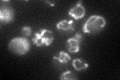
YMR089C
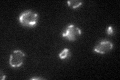
YMR089C

View description
Component, with Afg3p, of the mitochondrial inner membrane m-AAA protease that mediates degradation of misfolded or unassembled proteins and is also required for correct assembly of mitochondrial enzyme complexes
Localization:
Intensity:
Fold change:
Significance:
-
C’ GFP library in SD
mitochondria45.45 -
N' NOP1pr-GFP in SD

mitochondria74.7355 -
N' TEF2pr-mCherry in SD

mitochondria112.811 -
N' NATIVEpr-GFP in SD

punctate26.3598 -
N' TEF2pr-VC and Cyto-VN in SD

#N/A0 -
C’ GFP library in SD+DTT

mitochondria36.480.8No -
C’ GFP library in SD+H2O2

mitochondria41.340.9No -
C’ GFP library in Starvation Media
mitochondria56.141.23No -
C’ GFP library on the background of Pup2-DaMP

mitochondria -
C’ GFP library on the background of CCT mutant

mitochondria35.81720.787876No
